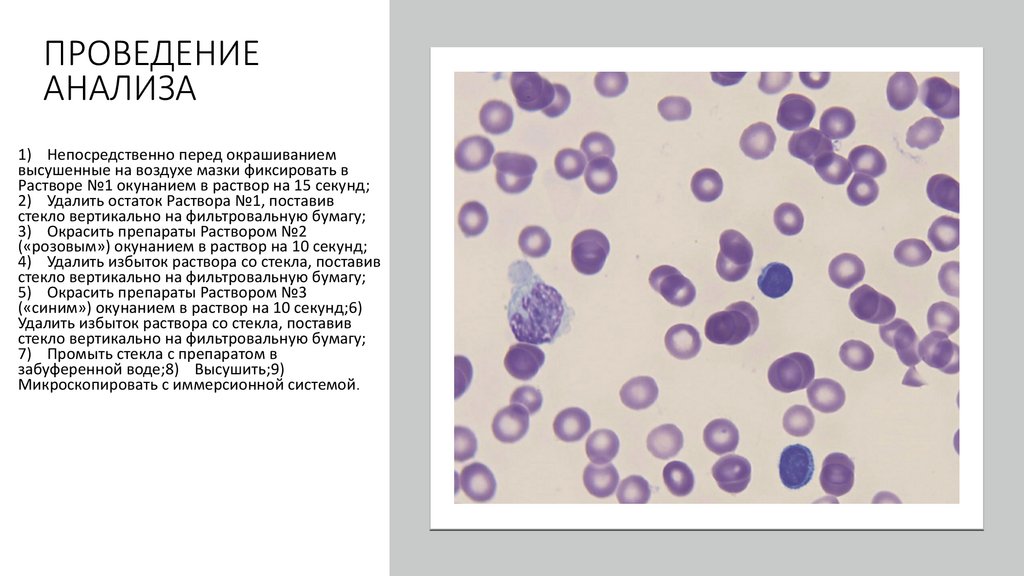
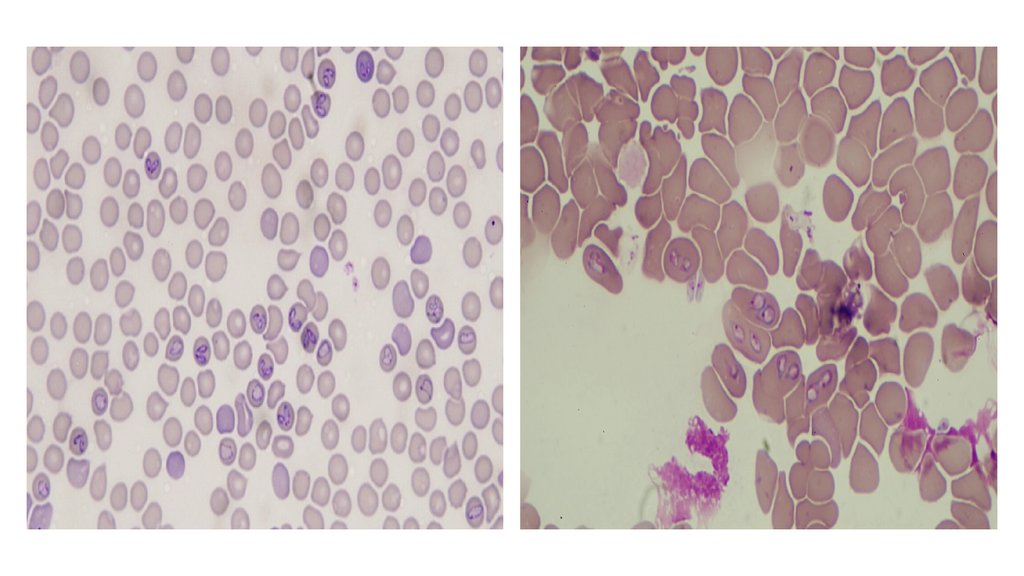
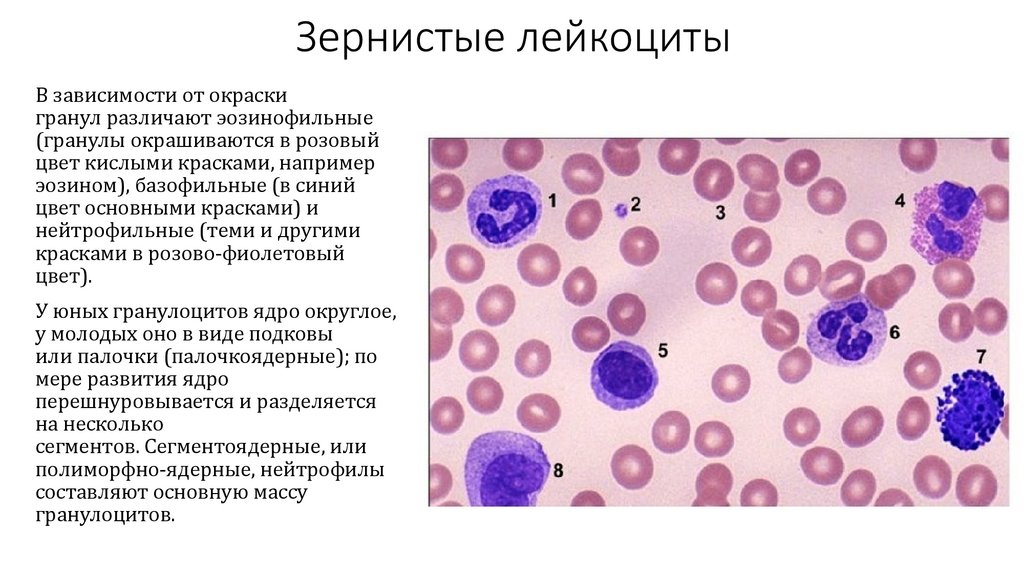
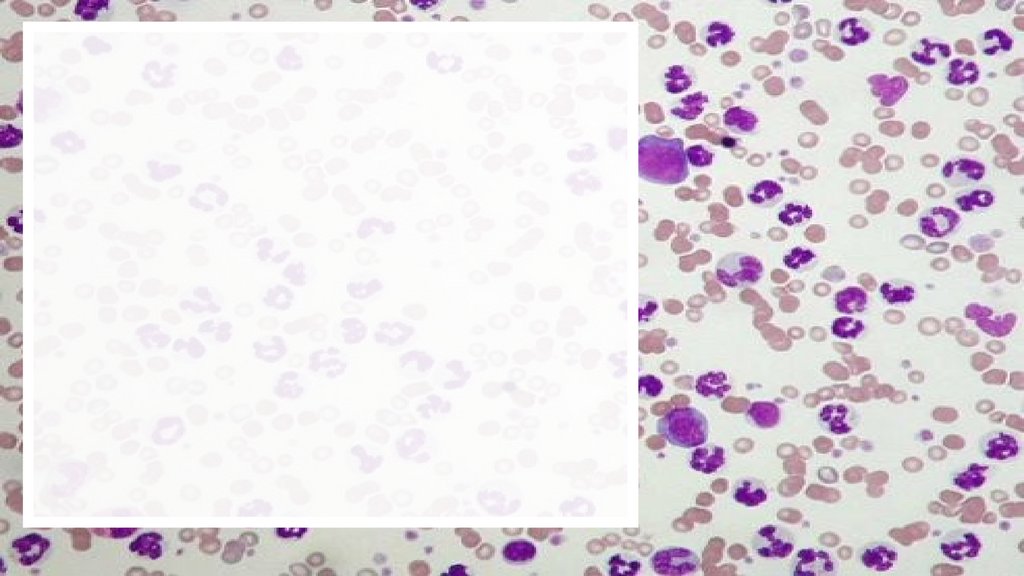
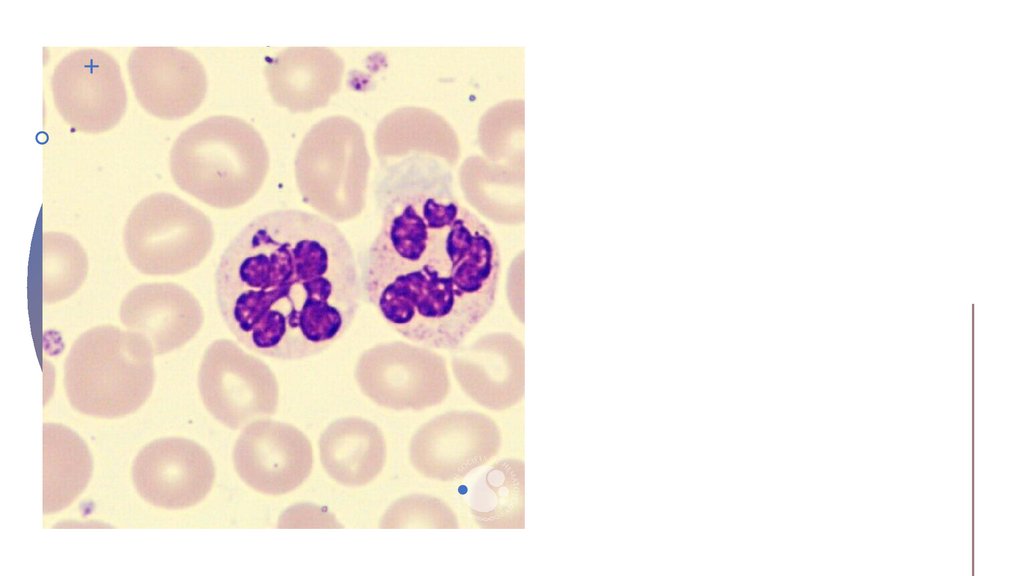
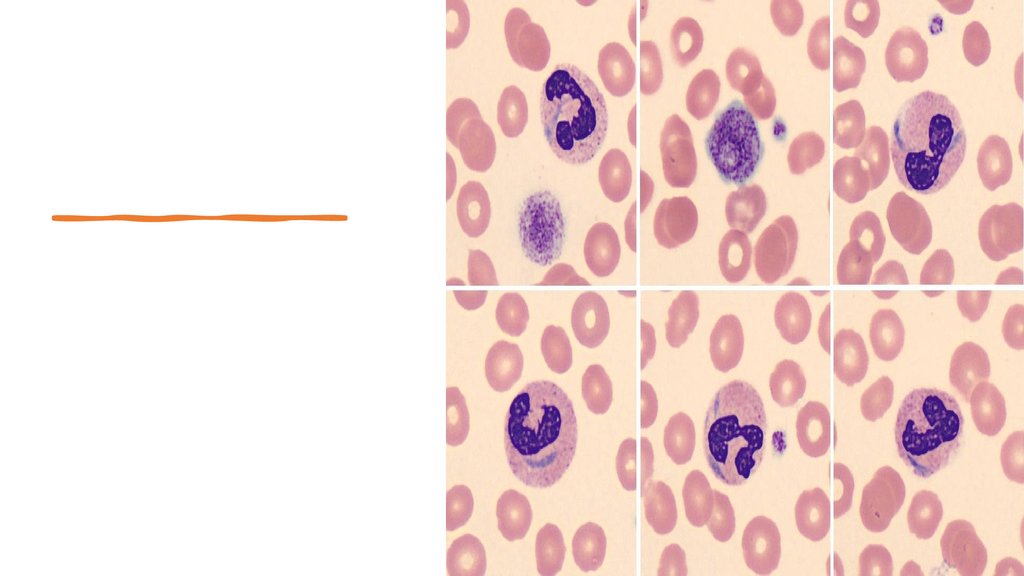

Similar presentations:
Ветеринарные курсы по цитологии Базовый уровень
1.
Ветеринарные курсы
по цитологии
Базовый уровень
Ветеринарный врач-цитолог:
Фридман Е.А.
2.
Немного о микроскопахМикроскоп — прибор для
получения увеличенных изображений
очень мелких объектов, не видимых
невооружённым глазом.
Рассматриваемый объект освещается
потоком света — от специальной
лампы или наведённым с помощью
встроенного зеркала.
Световой микроскоп даёт увеличение
в десятки, сотни и даже тысячи раз. С
его помощью можно рассмотреть
отдельные клетки многоклеточных
организмов, например клетки крови;
одноклеточные организмы —
простейших и бактерии.
3.
Классификация микроскоповОптические
Электронные
Сканирующие
зондовые
Рентгеновские
4.
Оптические микроскопы5.
Устройствомикроскопа
6.
Классификация объективов:Объективы разделяются по принципу расчетного
качества изображения, параметрическим и
конструктивно-технологическим признакам, а также
по методам исследования и контрастирования.По
классу изображения объективы могут быть:
ахроматическими;
планахроматическими;
полуапохроматическими ;
апохроматическими.
7.
Ахроматические объективыАхроматические объективы рассчитаны для
применения в спектральном диапазоне 486–656 нм.
Исправление любой аберрации (ахроматизация)
выполнено для двух длин волн. В этих объективах
устранены сферическая аберрация, хроматическая
аберрация положения, кома, астигматизм и частично
— сферохроматическая аберрация.
Изображение объекта имеет несколько синеватокрасноватый оттенок. При изменении фокуса образца
меняется и цветопередача, что затрудняет
интерпретацию результата.
8.
Планахроматические объективыВ планобъективах исправлена
кривизна изображения по полю,
что обеспечивает резкое
изображение объекта по всему
полю наблюдения. Кроме того,
объективы имеют и
ахроматическую коррекцию, что
позволяет их использовать
для рутинной работы.
Планахроматические
объективы
обычно применяются при
фотографировании и съемки
видео в медицине и биологии.
9.
Разница между ахроматическим и планахроматическимобъективами
10.
Полуапохроматические объективыПолуапохроматы - современные объективы,
обладающие промежуточным между планахроматами и
апохроматами качеством изображения. Полуапохроматы
имеют расширенную спектральную область, и
ахроматизация выполняется для трех длин волн. Они
выполняются из специальных стёкол, содержащих
флуорит.
Расширенная спектральная область позволяет им
применяться для флуоресцентной
микроскопии в УФ- диапазоне, что необходимо для
работы по методу FISH, а также в научных
исследованиях, где необходим дифференциальноинтерференционный контраст DIC.
11.
Маркировка объективовДанные о каждом объективе маркируются на его
корпусе с указанием следующих параметров:
маркировка типа оптической коррекции: планахромат (PLN, PLAN),
апохромат (АРО), планапохромат (Plan-Аро), Ахромат - ACH,
полуапохромат- UPLFLN
увеличение («х»-крат, раз): 10х, 40х, 100х; также дублируется по
международной системе маркировки : жёлтое кольцо -10х ,
зелёное кольцо - 20х, синее кольцо- 40х.
числовая апертура: 0,20; 0,65, пример: 40/0,65 или 40х/0,65;
коррекция на наличие покровного стекла - 0.17 или - (нет
коррекции);
коррекция на бесконечную дину тубуса - ∞;
дополнительная буквенная маркировка, если объектив
используется при различных методах исследования и
контрастирования: фазовый — Ph (PH2 — цифра соответствует
маркировке на специальном конденсоре или вставке),
поляризационный — P (Pol),
цветовая маркировка шрифта : красный- поляризационный
объектив, зелёный- фазово-контрастный объектив.
12.
Иммерсия (от лат. immersio — погружение) — жидкость,заполняющая пространство между объектом наблюдения и
специальным иммерсионным объективом (конденсором и
предметным стеклом). В основном применяются три типа
иммерсионных жидкостей: масляная иммерсия (МИ/Oil),
водная иммерсия (ВИ/W) и глицериновая иммерсия (ГИ/Glyc),
причем последняя в основном применяется в
ультрафиолетовой микроскопии.
Иммерсия применяется в тех случаях, когда требуется
повысить разрешающую способность микроскопа или её
применения требует технологический процесс
микроскопирования.
При этом происходит:
1)
2)
3)
повышение видимости за счет увеличения разности
показателя преломления среды и объекта
увеличение глубины просматриваемого слоя,
который зависит от показателя преломления среды.
Кроме того, иммерсионная
жидкость может уменьшать количество
рассеянного света за счет исчезновения бликов от
объекта. При этом устраняются неизбежные потери
света при его попадании в объектив.
13.
Основные правила хранения микроскопа и ухода за ним1. Микроскоп от проникновения внутрь пыли должен быть покрыт чехлом, лучше полиэтиленовым
(или стеклянным колпаком). Микроскоп может храниться в ящике или шкафу.2. Вынимая прибор из
ящика, снимая с полки, а также при переносе с места на место микроскоп необходимо одной рукой
держать за штатив, а другой придерживать за основание.3. Необходимо оберегать микроскоп от
механических ударов.4. Необходимо предохранять фронтальные линзы объективов и конденсора, а
также глазные линзы окуляров от соприкосновения с различными реактивами.5. Нельзя без
необходимости снимать бинокулярную насадку и прикасаться к поверхности тубусной линзы.6.
Нельзя касаться любой стеклянной поверхности пальцами рук, поскольку на поверхности остаются
жирные следы. Это потребует проведения внеплановой чистки оптики, которая может повлечь за
собой повреждение просветляющих поверхностей.7. Категорически запрещается снимать «рубашку»
(металлический корпус) объектива и заниматься его разборкой.8. Во внерабочем состоянии
микроскопа объективы должны быть опущены (при чем в ход лучей должен быть установлен
объектив малого увеличения). При этом объектив не должен касаться предметного столика.9. Для
продления срока службы ламп в осветителях рекомендуется не подвергать их резким перепадам
напряжения и перед включением и выключением переводить регулятор накала нити лампы
(реостат) в минимальное положение. Осветители, в которых отсутствует регулятор накала (реостат),
для продления срока службы лампы рекомендуется реже выключать.10. Раз в полгода необходимо
проводить профилактическую чистку и смазку микроскопа представителями сервисной
технической службы.
14.
Красители в цитологииДифф-квик
" + " - хорошо подходит для
окрашивания материала с
кожи, наружного слухового
прохода, влагалищного
мазка, поиска
гемопаразитов;
" - " - не подходит для
мазков крови и подсчета
лейкоформулы, поиска
опухолевых клеток в крови,
выпоте и коже.
15.
ПРОВЕДЕНИЕАНАЛИЗА
1) Непосредственно перед окрашиванием
высушенные на воздухе мазки фиксировать в
Растворе №1 окунанием в раствор на 15 секунд;
2) Удалить остаток Раствора №1, поставив
стекло вертикально на фильтровальную бумагу;
3) Окрасить препараты Раствором №2
(«розовым») окунанием в раствор на 10 секунд;
4) Удалить избыток раствора со стекла, поставив
стекло вертикально на фильтровальную бумагу;
5) Окрасить препараты Раствором №3
(«синим») окунанием в раствор на 10 секунд;6)
Удалить избыток раствора со стекла, поставив
стекло вертикально на фильтровальную бумагу;
7) Промыть стекла с препаратом в
забуференной воде;8) Высушить;9)
Микроскопировать с иммерсионной системой.
16.
ЛейкоДиф 200Ручной метод гематологического анализа, подготовка к
микроскопированию. Мазки крови подсушивают на воздухе,
фиксируют в растворе R1, поочередно погружают в готовые растворы
R2 и R3.
Интенсивность окраски можно регулировать числом погружений в
раствор красящих веществ, но не менее 3 раз.
Для эозинофильного окрашивания - в забуференный краситель эозина,
для базофильного окрашивания - буферизованный раствор азура.
Растворы устойчивы, но их необходимо защищать от воздействия
прямого солнечного света. Если результат окрашивания мазка
отличается от стандарта, то следует заменить растворы (обычно - раз в
неделю).
Если расчет лейкоцитов окажется патологическим, то следует провести
контрольное исследование по Май-Грюнвальду или РомановскомуГимзе. Данный набор не подходит для изучения тромбоцитов и
неинтенсивно выделяет грануляцию базофилов.
17.
Стандартныекрасители
Фиксаторкраситель
эозинметиленовый
синий по
МайГрюнвальду
Краситель
Азур-эозин по
Романовском
у
18.
Методикаокраски
Высушенный мазок крови опускаем в первый раствор - фиксатор (эозин-метиленовый
синий) на 5-10 минут;
Далее промываем под холодной водой 10 – 15 секунд;
Смешиваем буферный раствор со вторым красителем (азур-эозин) из расчета 15 мл
буфера + 5 мл красителя, покрываем этим раствором мазки и ждем 15-30 минут;
Промываем повторно под холодной водой стекла около 20 секунд и высушиваем;
Микроскопию проводим при иммерсии.
19.
20.
Техника приготовления мазка кровиКаплю крови наносят на сухое предметное стекло, далее
под углом в 45 градусов подносят шлифовальное стекло.
Кровь растекается по краю шлифовального стекла, затем
быстрым движением шлифовальное стекло продвигают вперед,
скользя по поверхности предметного.
Кровь тонким слоем размазывается по предметному стеклу,
получаем монослой клеток!
21.
Варианты правильных и неправильныхмазков крови
22.
ЛейкоцитыЛейкоци́ ты — неоднородная группа
различных по внешнему виду и функциям
клеток крови человека и животных,
выделенная по признакам наличия ядра и
отсутствия самостоятельной окраски.
Образуются в красном костном мозге,
обнаруживаются во всём организме
животного. Продолжительность жизни
лейкоцита колеблется от нескольких часов
до нескольких лет. Главная функция
лейкоцитов — защита организма
от патогенов и удаление продуктов
разрушения тканей.
23.
Белые кровяные клеткиимеют цитоплазму и ядро.
Их подразделяют на две
большие
группы: зернистые
(гранулоциты) и
незернистые
(агранулоциты).
В цитоплазме
зернистых лей коцитов
содержатся зернышки
(гранулы), в цитоплазме
незернистых гранулы
отсутствуют.
24.
Зернистые лейкоцитыВ зависимости от окраски
гранул различают эозинофильные
(гранулы окрашиваются в розовый
цвет кислыми красками, например
эозином), базофильные (в синий
цвет основными красками) и
ней трофильные (теми и другими
красками в розово-фиолетовый
цвет).
У юных гранулоцитов ядро округлое,
у молодых оно в виде подковы
или палочки (палочкоядерные); по
мере развития ядро
перешнуровывается и разделяется
на несколько
сегментов. Сегментоядерные, или
полиморфно-ядерные, ней трофилы
составляют основную массу
гранулоцитов.
25.
Незернистые лейкоцитыОни делятся на лимфоциты и моноциты.
Лимфоциты имеют крупное ядро, окруженное узким поясом
цитоплазмы. В зависимости от размера различают большие,
средние и малые лимфоциты. У лошадей и плотоядных
преобладают сегментоядерные ней трофилы —
ней трофильный профиль, у других - лимфоцитарный .
Моноциты — самые большие клетки крови, в основном
округлой формы, с хорошо выраженной цитоплазмой .
Процентное соотношение различных форм лей коцитов
называют лей коцитарной формулой (лейкоформулой)
или лейкограммой. Она имеет видовые отличия и
характерно изменяется при инфекционных и
паразитарных заболеваниях, поэтому ее изучению придается
большое значение в клинике.
26.
ПРОДОЛЖИТЕЛЬНОСТЬ ЖИЗНИ
ЛЕЙКОЦИТОВ
Большинство из них живет относительно
недолго. При помощи методики меченых
атомов установлено, что гранулоциты живут
максимум 8—10 дн., чаще значительно
меньше — часы и даже минуты.
Средняя продолжительность
жизни ней трофилов составляет 5 ч. Среди
лимфоцитов различают короткоживущие и
долгоживущие формы. Первые (Влимфоциты) живут от нескольких часов до
недели, вторые (Т-лимфоциты) могут жить
месяцы и даже годы.
27.
Лейкоцитоз и лейкопенияУвеличение количества лей коцитов называют лейкоцитозом, а уменьшение
— лейкопенией.
Различают два вида лейкоцитозов: физиологический и реактивный.
Физиологический, в свою очередь, делят на: 1) пищеварительный
(значительное увеличение количества лей коцитов происходит после
приема корма; особенно выражен у лошадей , свиней , собак и кроликов); 2)
миогенный (развивается после тяжелой мышечной работы); 3) эмоциональный ; 4)
при болевых воздей ствиях; 5) при беременности.
Реактивные, или истинные, лей коцитозы бывают при воспалительных
процессах, инфекционных заболеваниях. При этом резко усиливается
образование белых кровяных телец в органах кроветворения и количество
лей коцитов в крови увеличивается значительнее, чем при
перераспределительном лей коцитозе. Но главное отличие заключается в том, что
при реактивных лей коцитозах меняется лей коцитарная формула : в крови
увеличивается количество молодых форм ней трофилов — миелоцитов,
юных, палочкоядерных. По ядерному сдвигу влево оценивают тяжесть
заболевания и реактивность организма .
28.
Кинетика лейкоцитовНейтрофилы 5-10 ч в кровотоке.
½ в общем кровотоке;
½ в капиллярном звене (улавливается).
Пул циркулирующий и пул
маргинальный (пристеночный резерв).
У собак как правило 1:1 (М:Ц);
У кошек 3:1 (М:Ц).
Псевдонейтропения - уходят в
капилляры.
Псевдонейтрофилия - выходят из
капилляров.
29.
Сдвиг1)
2)
Левый - увеличение количества палочкоядерных
нейтрофилов/метамиелоцитов/миелоцитов. Часто острое воспаление.
Правый - гиперсегментированные нетрофилы повышаются, увеличение времени
циркуляции. Влияние оказывает применение глюкокортикоидов. Артефакт "старой крови".
30.
Левый сдвигРегенеративный - реакция ККМ на воспаление
адекватная - молодые формы < сегменты;
Дегенеративный - молодые формы >
сегменты;
Продукция и выпуск нейтрофилов недостаточен,
плохой прогноз (сепсис, эндотоксемия, ожог,
перитонит, пневмония, плеврит).
Дегенеративным считается сдвиг при > 10% от
всех лейкоцитов молодых форм
(миелоциты/метамиелоциты/палочкоядерные).
31.
Типы лейкограмм1.
Стрессовая:
Лейкоциты или
;
Зрелые нейтрофилы , выход из ККМ;
Лимфоциты , перераспределение циркулирующих лимфоцитов;
Моноциты
Нет токсических изменений в клетках;
Эозинофилы могут
;
Может быть гиперсегментация нейтрофилов (глюкокортикоидов
влияние).
4 часа после стресса/ пик 6-8 часов/ долго начинается и долго
проходит.
32.
2. Физиологическая:Влияние эпинефрина, является ответом на возбуждение, чаще у
кошек и щенков, непатологическая, сразу после эпизода
возбуждения (быстро проходит примерно в течении 30 мин)
Лейкоциты
или
;
Зрелые нейтрофилы , отторгаются от эндотелия;
Нет левого сдвига и изменения морфологии;
Малые лимфоциты ;
Могут увеличиваться моноциты и эозинофилы (не всегда).
33.
3. Воспалительная:Чем выше запрос в ткани, тем больше
производит КМ, такое воспаление как
минимум продолжается несколько дней
(острое/хроническое).
Нейтрофилия;
Моноцитоз;
Изменения (токсические нейтрофилы,
активированные макрофаги, реактивные
лимфоциты).
34.
3.1. Острый типвоспалительной
лейкограммы
Запрос в ткани выше резерва
КМ;
Начинается через 6-8 часов
после первичной стимуляции
воспалением;
Лейкоцитоз + левый сдвиг;
Палочки > метамиелоциты >
миелоциты;
Могут быть токсические
изменения в нейтрофилах и
моноцитов.
35.
3.2. Хронический типвоспалительной
лейкограммы
Продолжительность воспаления
варьирует от нескольких дней до
нескольких недель;
Лейкоцитоз + зрелая
нейтрофилия
(гиперсегментация);
Левого сдвига нет, либо он очень
слабый;
В КМ тем временем
гранулоцитарная гиперплазия.
36.
4. Воспалительнаялейкограмма с компонентом
стрессовой
Воспаление
(нейтрофилия);
Лимфопения;
Как дифференцируем
от стрессовой?
А вот так: есть ли
признаки
воспаления?
(моноцитоз,
изменения
токсические в
лейкоцитах).
37.
5. Воспалительнаялейкограмма с
компонентом
физиологической
Воспаление (нейтрофилия);
Лимфоциты слабо повышены;
Как дифференцировать от
физиологической?
А вот так: есть ли признаки
воспаления? (моноцитоз,
изменения в морфологии
клеток).
38.
6. Очень воспалительная(лейкемоидная реакция)
Лейкоциты сильно завышены ( до 50-100 тыс/мкл и
выше!)
Регенеративный левый сдвиг;
Моноцитоз;
Токсические изменения в нейтрофилах (+/-);
Реактивные лимфоциты (+/-).
Сложно дифференцировать от хронической
миелоидной лейкемии.
Причины: пиометра, пиоторакс, пиелонефрит,
хроническое воспаление, ИОГА, паранеопластический
синдром, очаги некроза.
39.
7. Лейкемия(лейкоз)
Бласты в циркулирующем русле;
Лейкоциты могут быть низкими или
нормальными (исследовать
костный
мозг/лимфоузлы/селезенку);
Атипичные клетки в крови +
Острая реакция и хроническая (ИГХ,
проточная цитометрия, PARR).
40.
Спасибо завнимание!

medicine
medicine








